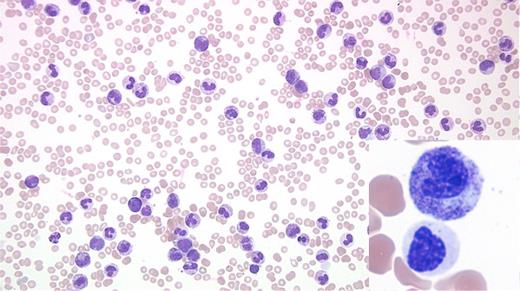
Image Challenge May June 2017. / Image Challenge May June 2017

A 76-year-old man with a history of bladder cancer treated with two local resections and no chemotherapy or radiation was transferred from an outside hospital with hyperleukocytosis and an abnormal complete blood count (white blood cell count, 162 cells/μ; hemoglobin 8.2 g/dL; and platelet 43 K/uL) in 2017. His medical history was significant for mild leukocytosis and skin infections in 2006. Evaluation of peripheral blood revealed leukocytosis due to neutrophilia with two distinct subsets of neutrophils (Figure). Examination of marrow also showed abnormal findings.
Image Challenge May June 2017
A. Chronic myeloid leukemia, BCR-ABL1+
B. Leukemoid reaction
C. Atypical chronic myeloid leukemia
D. Chronic neutrophilic leukemia
Sorry, that was not the preferred response.
Correct!
The peripheral blood smear shows leukocytosis due to neutrophilia and some left shifted myeloid cells with two distinct morphologic subsets of neutrophils. The majority of the Figure shows toxic granulation, toxic vacuolation, and Döhle bodies, while the inset exhibits distinct dysplastic changes (nuclear hyposegmentation, abnormally condensed chromatin, and hypogranular cytoplasm). No peripheral blood basophilia, eosinophilia, or increased blasts are noted. Bone marrow evaluation revealed 100 percent cellular core with marked granulocytic proliferation with a left-shifted maturation and a population of dysplastic granulocytes along with markedly reduced erythropoiesis, and small and hypolobated megakaryocytes without any increase in blasts.
Karyotype analysis reveals a clonal t(7;17) (q22;q11.2) abnormality in 45 percent of the examined cells. Florescence in situ hybridization for BCR/ABL1 translocation, PDGFRB translocation, and 4q12 (PDGFRA-KIT) rearrangement was negative. CEBPA mutation detection by next-generation sequencing (NGS) was negative. Reverse-transcription polymerase chain reaction t(9;22) was negative for p210 and p190 transcripts. Large panel next-generation sequencing (NGS) reveals four distinct pathogenic mutations: two involving CSF3R (p.S810Qfs*6), and CSF3R (T618I), with additional mutations in SF3B1 and RAD21. The first mutation in the CSF3R gene leads to a premature C-terminal truncation resulting in dysregulation of SRC family-TNK2 kinase signaling. The second CSF3R produces a threonine to isoleucine substitution at amino acid 618. This results in dysregulation of JAK family kinase signaling. CSF3R mutations are seen in the majority of chronic neutrophilic leukemia (CNL) cases, but have been reported in less than 10 percent of atypical chronic myeloid leukemia (aCML).1,2
The above findings allowed classification as atypical CML, BCR-ABL1-negative. Because this entity is characterized by overlapping myeloproliferative features (leukocytosis and splenomegaly) and myelodysplastic features, it is currently classified under myelodysplastic/myeloproliferative neoplasm.3 Most such cases usually present with more striking granulocytic dysplasia. The patient was treated with off-label JAK2 inhibitor (ruxolitinib) and hydroxyurea with marked improvement in hemoglobin and platelet count as well as marked clinical improvement (resolution of splenomegaly and fatigue). The other important diagnostic considerations are CML and CNL. While there is peripheral blood neutrophilia with left shift and hypercellular marrow with small megakaryocytes, the presence of dysplasia and absence of BCR-ABL1 fusion allows exclusion of CML. Interestingly, the presence of CSF3R-T618I mutation and other CSF3R activating mutations have been included as part of the diagnostic criteria for CNL in 2016 WHO classification of myeloid neoplasms and acute leukemia.1 However, the diagnosis of CNL requires absence of dysplasia.
While leukemoid reaction resulting from a reactive process such as acute/chronic infection or an inflammatory disorder is certainly a possibility, the presence of clonal abnormalities (translocation and mutations) and morphologic dysplasia allows exclusion of a leukemoid reaction. The case highlights the need to carefully look for dysplasia even in cases that otherwise seemingly present with an infectious/leukemoid blood picture.
References
References
The authors indicated no relevant conflicts of interest.
Submitted by Shiraz Fidai, MD, Sahr Syed, MD, Sandeep Gurbuxani, MBBS, PhD, Kristen Pettit, MD, and Olatoyosi Odenike, MD.